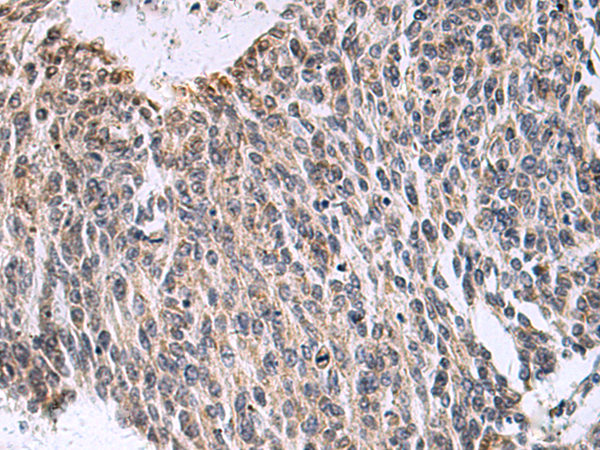

-
分类: 科研抗体货号: P05745别名: HHS; HTS; B7323; HYPT1; DRAPC1; FP7019应用: WB反应种属: Human, Mouse
-
分类: 科研抗体货号: P05773别名:应用: IHC反应种属: Human
-
分类: 科研抗体货号: P05728别名:应用: IHC反应种属: Human
-
分类: 科研抗体货号: P05744别名: SWI; ISWI; SWI2; SNF2L; SNF2L1; SNF2LB; SNF2LT; NURF140应用: IHC反应种属: Human, Mouse
-
分类: 科研抗体货号: P05767别名:应用: IHC反应种属: Human, Mouse, Rat
-
分类: 科研抗体货号: P05714别名: PAR2; GPR11应用: IHC反应种属: Human, Mouse, Rat
-
分类: 科研抗体货号: P05837别名: C7; IFI10; INP10; IP-10; crg-2; mob-1; SCYB10; gIP-10应用: IHC反应种属: Human, Mouse, Rat
-
分类: 科研抗体货号: P05763别名: M-RAs; RRAS3; R-RAS3应用: WB反应种属: Human, Mouse, Rat
-
分类: 科研抗体货号: P05712别名: P311; PTZ17; SEZ17; D4S114; C5orf13; PRO1873应用: WB,IHC反应种属: Human, Mouse, Rat
-
分类: 科研抗体货号: P05824别名: EFL6; EPLG8; LERK8应用: WB,IHC反应种属: Human, Mouse

鄂公网安备42018502007531号
鄂公网安备42018502007531号

